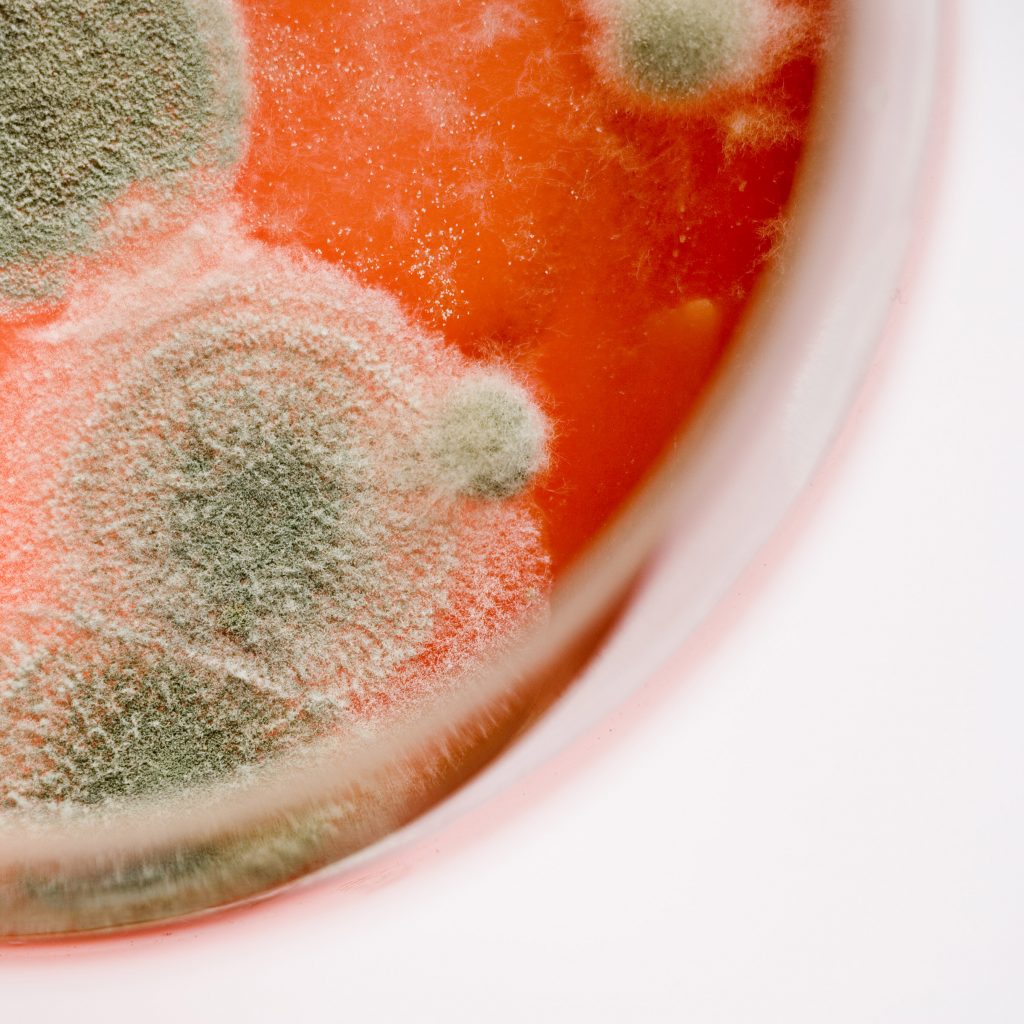
Alimente mucegăite
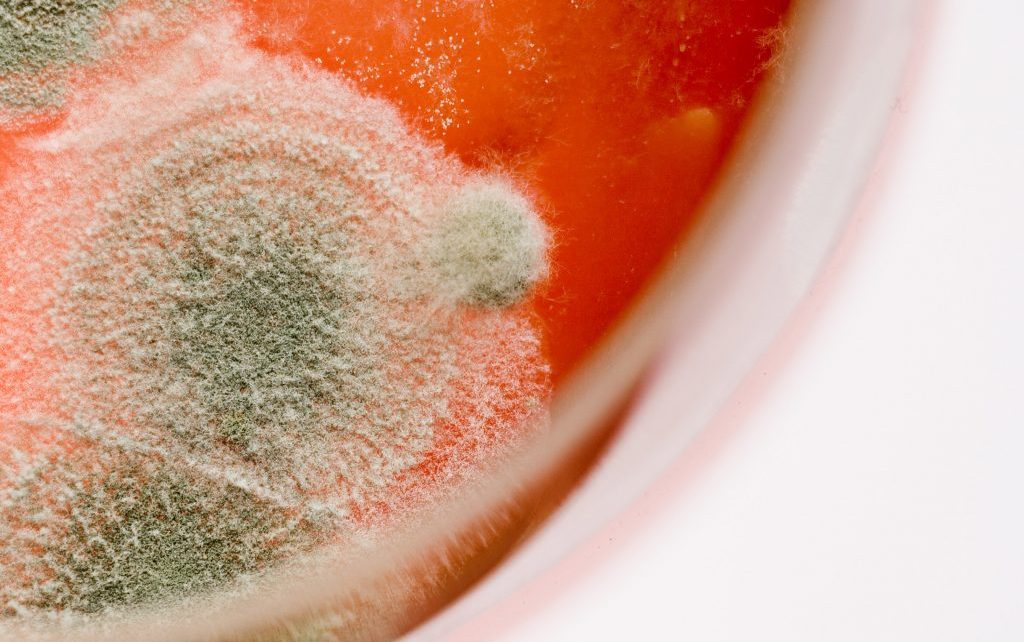

- Cele mai multe gospodarii văd mucegai pe alimente și le aruncă, dar există unele produse pe care le poți salva, potrivit unui expert.
- Alice Beer, expertul în consum al emisiunii This Morning, a dezvăluit că nu toate alimentele mucegăite sunt periculoase și că există unele produse „stricate” care pot fi consumate în siguranță.
- Multe dintre alimente sunt aruncate la gunoi pentru că nu mai sunt în stare bună, sau uneori au urme de mucegai.
Cele mai multe gospodarii văd mucegai pe alimente și le aruncă, dar există unele produse pe care le poți salva, potrivit unui expert.
Alice Beer, expertul în consum al emisiunii This Morning, a dezvăluit că nu toate alimentele mucegăite sunt periculoase și că există unele produse „stricate” care pot fi consumate în siguranță.
Multe dintre alimente sunt aruncate la gunoi pentru că nu mai sunt în stare bună, sau uneori au urme de mucegai.
Dar, există unele produse pe care le poți mânca, chiar dacă au prins mucegai.
Alice a spus: „Suntem foarte obișnuiți cu mâncarea perfectă, suntem obișnuiți să mergem la supermarket, să punem mâna în spatele unui raft și să luam un produs care are o săptămână termen de valabilitate.
„În prezent, nu mai avem parte de așa ceva, există goluri pe rafturi, iar lucrurile nu mai au durata de viață pe care o aveau înainte, lucrurile se strică. Salata pe care în mod normal o lăsăm în frigider câteva zile, a doua zi prinde mucegai.”
„Fructele – zmeura care oricum nu rezistă niciodată mult timp, dar la 24 de ore de la cumpărare s-a mucegăit?
„Ceea ce avem în frigider, sunt alimente care nu arată la fel de perfect cum suntem obișnuiți. Dar ceea ce trebuie reținut este că mucegaiul și bacteriile au nevoie pentru a supraviețui de umiditate, căldură și aer, iar dacă ceva are deja un conținut ridicat de umiditate, atunci va avea mucegai pe el mai repede și se va răspândi prin el rapid.”
Brânză moale – Dacă există mucegai pe o zonă sau pe exterior, nu o tăia sau răzui și nu o mânca, „probabil că mucegaiul a pătruns prin ea”, a spus Alice. Cel mai bine este să o arunci la gunoi.
Brânză albastră – Este făcută cu mucegai și este comestibilă, dar numai pentru că mucegaiul este folosit în procesul alimentar, la fel ca la salam și alte mezeluri. Se poate mânca în siguranță.
Brânză tare – „Daca vezi mucegai pe partea exterioară a unei brânzeturi tari, cum ar fi cașcavalul sau parmezanul, atunci este în regulă să îl tai”, a explicat Alice.
Fructe și legume – Micile pete de mucegai pot fi, de obicei îndepărtate – atât timp cât nu sunt lipicioase, deoarece acest lucru semnalează prezența bacteriilor care pot provoca intoxicații alimentare sau dureri de stomac. Tăierea în jurul și sub petele de mucegai de pe legumele ferme, cum ar fi rădăcinoasele și varza, ar trebui să le facă sigure pentru a fi consumate. Conținutul lor scăzut de umiditate și nivelurile adesea mai ridicate de aciditate îngreunează pătrunderea mucegaiului.
Merele – fii atent deoarece în merele stricate sau mucegăite se poate găsi o toxină numită patulină.
Fructe și legume moi, cum ar fi castraveții, roșiile, piersicile – „Nu vei putea vedea unde a intrat mucegaiul, aruncă -le”, a sfătuit Alice. „Chiar dacă este o bucățică mică la exterior, nu, nu aș lua-o și nu aș mânca-o, pentru că nu știi ce mucegai invizibil este acolo”.
Este periculoasă mâncarea mucegăită?
Prea mult din orice fel de mucegai îți va provoca o intoxicație alimentară de grad înalt sau de grad scăzut.
Expertul în mucegaiuri, Dr. Patrick Hickey insistă că ciupercile joacă un rol cheie în îmbunătățirea gustului, texturii și valorii nutritive a ceea ce mâncăm și pot face ca acestea să fie mai ușor de digerat. „Fără ciuperci, berea și pizza nu ar exista”, a precizat el pentru BBC Food.
Deși este rar ca oamenii să se intoxice acut, Dr. Hickey spune că se cunosc relativ puține lucruri despre efectele pe termen lung ale ingerării unor cantități mici de toxine fungice (mucegai), avertizând că „există îngrijorarea că, dacă sunt consumate în mod repetat, micotoxinele pot provoca efecte cumulative și pot duce la îmbolnăvire”.
Agenția pentru Standarde Alimentare (FSA) recomandă să nu se consume nici un aliment care conține mucegai, subliniind că acest lucru este deosebit de important pentru grupurile vulnerabile, cum ar fi copiii, persoanele în vârstă, femeile însărcinate și persoanele cu un sistem imunitar slăbit. Dr. Hickey spune că unele alimente pot fi salvate, „dar faci acest lucru pe propriul risc. Dacă nu ești sigur, nu o mânca.”
O modalitate de a reduce riscul de mucegai este depozitarea corectă a alimentelor.
The post Alimente mucegăite pe care le poți mânca in siguranță. Nu-ți vor face nici un rău appeared first on Aleph News.
potrivit alephnews
Împotriva articolelor redacției noastre, persoanele nemulțumite pot formula Contestație în termen de 10 zile de la publicarea articolului, la judecătoria Orășenească nr. 1 München Bayern Deutschland, in conformitate cu Legea federală Germană. Considerăm că nu se pot formula acțiuni la instanțele din România deoarece nici o persoană care activează în trustul nostru nu poate fi extrasă de sub jurisdicția federală germană. Considerăm că redacția noastră nu răspunde în fața autorităților din România ci doar celor federale sau civile germane. deoarece legea română nu are efecte de extraneitate asupra redacției chiar dacă subiectul știrilor face obiectul unor evenimente sau persoane din România și sunt scrise în limba română. Limba română nu este izvor de extraneitate a legii.